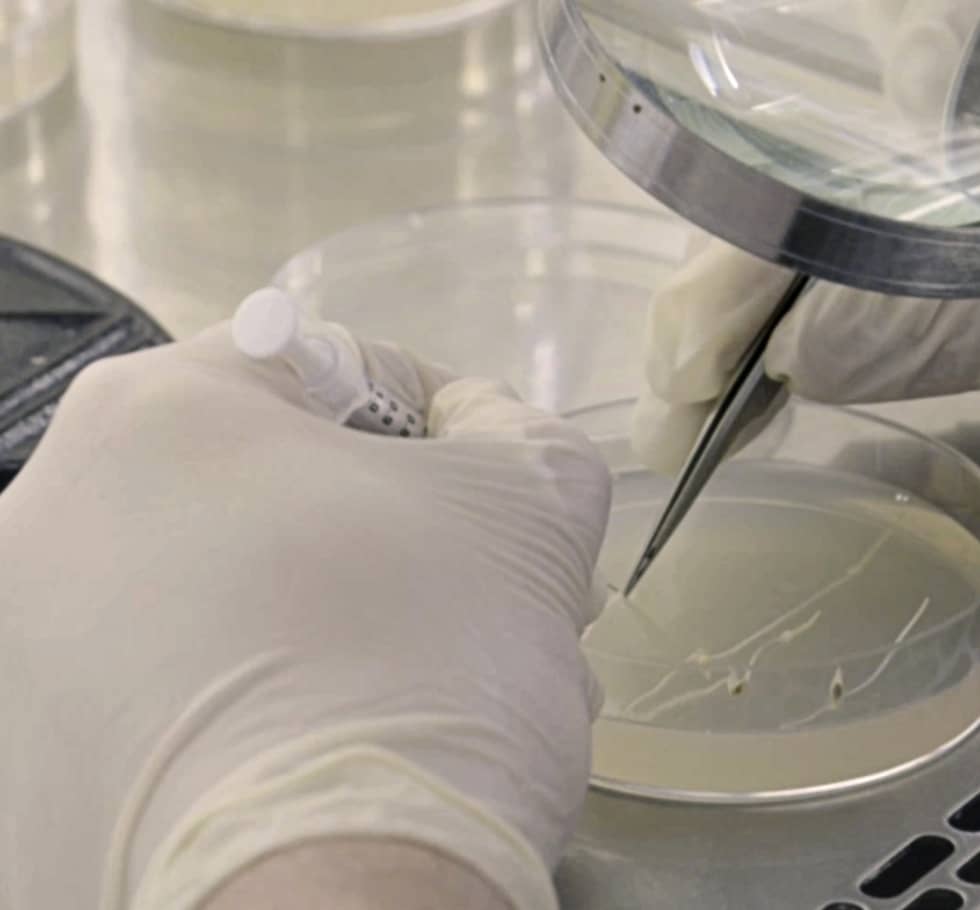

Our story

100% local
Home-grown and hands-on from the ground up, working for the good of NZ farmers.

When you choose Cropmark, you get products designed for this part of the world, developed by locals whose ag roots run deep nationwide, and stretch back decades. Call us one-sided, but we believe unique, world-class farm systems deserve unique, customised solutions.
Open and agile
Close enough to listen carefully, flexible enough to respond fast.

Our best ideas come from you – your issues, opportunities, expectations and needs. Now, more than ever, growing food to help nourish the world means embracing change, and trying new things. Sometimes it’s not easy, but we’re always ready to take on the challenge.
Capable
Founded by technical specialists in 2000, and still driven by research, science and innovation today.

Our record of plant breeding and new product development speaks for itself. But what you may not know is how much of that innovation has come from within. It all happens here, thanks to a team of scientists and researchers as focused on successful, sustainable farming as you are.
Supportive
Knowledge is power; we share ours, and learn from yours.

Great results are a team effort, and advanced pasture and forage performance is no exception. We’ve seen what’s possible when our technical expertise meets your skill and understanding, so we constantly work with farmers and agri professionals to get the very best out of our products.
Proactive
We play the long game, with one eye always on what the future might bring.
Agriculture has been evolving for thousands of years, but now changes are coming faster than ever before. Helping you meet the challenges and opportunities of today is only part of our job; the rest is about searching for solutions that will make your farm better years from now.
Knowledge Hub
Knowledge is power; We share ours.
Explore practical tips, insights, and research-backed advice to help you get the best from your pastures and crops.
View knowledge hub










